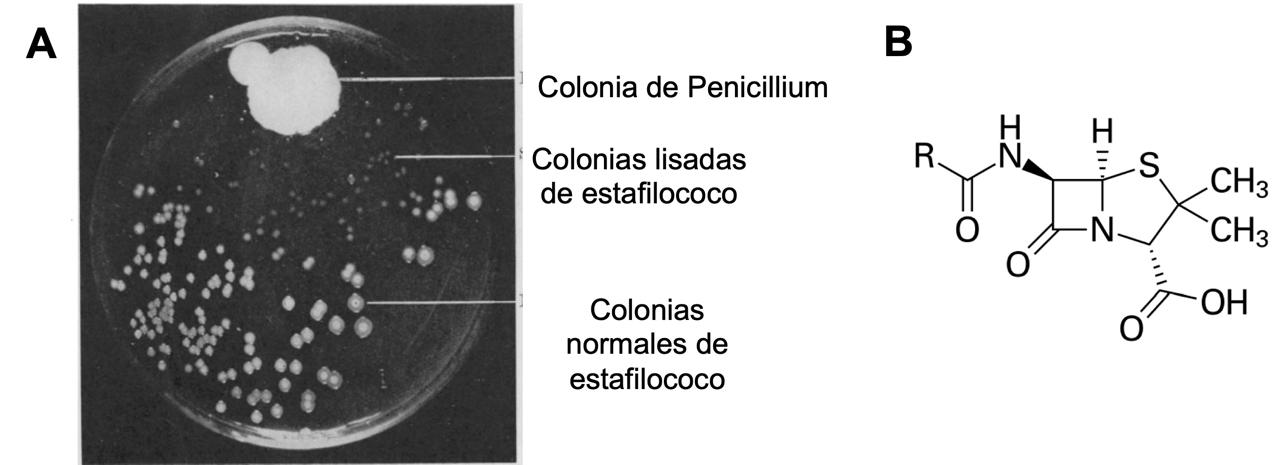

¡Qué curioso!
David Romero Camarena
El Dr. Romero es investigador del Centro de Ciencias Genómicas de la Universidad Nacional Autónoma de México, en Cuernavaca, Morelos. Su área de especialidad es la genómica bacteriana, con énfasis en mecanismos de cambio en genomas. Es miembro y expresidente de la Academia de Ciencias de Morelos.
Esta publicación fue revisada por el comité editorial de la Academia de Ciencias de Morelos.
La frase más emocionante de escuchar en ciencia, la que anuncia nuevos descubrimientos, no es “¡Eureka!” (¡Lo encontré!) sino “¡Qué curioso!”
Isaac Asimov (1920-1992)
Por vocación y por elección soy científico y eso significa que soy un preguntón y buscador de respuestas profesional. No cualquier pregunta, desde luego. Para un científico las preguntas son acerca de la naturaleza (¿qué pasa?, ¿cómo ocurre?) y buscamos identificar aquello para lo cual no hay todavía una respuesta conocida (¿por qué ocurre?, ¿cómo se explica?). Los campos en los que trabajamos los científicos son en buena medida un interés y curiosidad personal y abarcan todas las áreas del conocimiento. Para ello, empleamos el método científico, acompañado de nuestra imaginación y creatividad. Y sí, la verdad es muy satisfactorio cuando planteamos una pregunta, colectamos datos por experimentación o por observación, e imaginamos una respuesta que explique satisfactoriamente lo hallado: los momentos ¡lo encontré! de los que habla Asimov.
Pero los momentos más emocionantes para un científico son aquellos en los que, en el curso de una investigación, uno se topa con resultados inesperados, con observaciones inexplicables según las teorías del momento o que de plano las contradicen. Solemos entonces decir, como Asimov, ¡Qué curioso! Son momentos que estimulan la imaginación y la hacen ir por nuevos caminos y plantear respuestas que pueden ser revolucionarias. En inglés, se usa el término serendipity para referirse a ellos. El Dr. Ruy Pérez Tamayo, gran científico y elegante divulgador mexicano, define a la serendipia como "la capacidad de hacer descubrimientos por accidente y sagacidad, cuando se está buscando otra cosa". La serendipia no es, como decimos en México, solamente una chiripada. Hay un poco de azar en encontrarlos, pero se requiere sagacidad, imaginación y mucho tesón para convertir esas observaciones en explicaciones que lleven a conocimiento. Aunque puedan parecer infrecuentes, en realidad ocurren más a menudo de lo que parece. Acompáñenme a descubrir algunos ejemplos de esos “momentos estelares” en la ciencia.
Un rayo misterioso
En 1895, el físico alemán Wilhelm Röntgen estaba estudiando la fluorescencia, un efecto que se produce cuando al incidir una luz de una cierta longitud de onda sobre algunos materiales los lleva a emitir una luz con una diferente longitud de onda. Para ello, estaba empleando un tubo de rayos catódicos, un tubo de vidrio al vacío donde al pasar una corriente eléctrica se produce una emisión de electrones. Röntgen, a diferencia de otros investigadores, empleó un tubo de rayos catódicos con una pared de vidrio más gruesa que los tubos comúnmente empleados. El experimento funcionaba, produciendo lo que parecía ser fluorescencia. Röntgen esperaba que, si obstruía las emisiones con un filtro, como un trozo de cartón, la “fluorescencia” desapareciera. Sin embargo, eso no pasó. Probó diferentes filtros y la “fluorescencia” no desaparecía. ¡Qué curioso! No parecía ser fluorescencia. Solo pudo impedir la producción de “fluorescencia” al colocar una lámina de plomo entre el tubo de rayos catódicos y el material fluorescente. Parecía un nuevo tipo de rayos, que por lo misterioso que le parecían, los llamó rayos X. Estos rayos se producen cuando los electrones se frenan repentinamente al chocar contra un blanco dentro del tubo de rayos catódicos.
Röntgen trató de detener esos rayos con un filtro poco usual: su propia mano. Su sorpresa no tuvo límites: lo que vio sobre el material fue la imagen de los huesos de su mano. Logró convencer a su esposa Anna Bertha Ludwig de que le diera su mano nuevamente... pero para hacer experimentos. Expuso la mano de su esposa a los rayos X, capturando la imagen en una placa fotográfica. Produjo así la primera radiografía conocida (Figura 1A), que fue seguida, días después, por una radiografía de la mano de su compañero Albert von Kölliker (Figura 1B).

Figura 1. Las primeras radiografías producidas ¡con todo y anillos! (A) La mano de la esposa de Röntgen, Anna Bertha Ludwig; (B) la mano de Albert von Kölliker (Fuente: https://en.wikipedia.org/wiki/Wilhelm_R%C3%B6ntgen).
Este es un buen ejemplo de serendipia. Estudiando un fenómeno (la fluorescencia) se topó con otro fenómeno (la producción de rayos X), interpretándolo correctamente. Sus experimentos lo llevaron también a descubrir una aplicación médica de sus hallazgos, comenzando el campo de la radiología. No es de extrañar que sus hallazgos le llevaran a ganar el Premio Nobel de Física en 1901.
Energía en la oscuridad
En 1896, el físico francés Antoine Henri Becquerel se enteró de los experimentos de Röntgen. Becquerel estaba estudiando la fosforescencia, un fenómeno relacionado a la fluorescencia, pero donde el material fosforescente continúa emitiendo luz por un tiempo largo después de ser iluminado. Había estado trabajando con una sal doble de uranilo y potasio (K2UO2(SO4)2), la cual fosforecía al exponerse a la luz del sol. Intrigado por el reporte de Röntgen, se le ocurrió que tal vez la fosforescencia que detectaba se debía a la producción de rayos X en este material.
Para probar su idea, expuso la sal doble de uranilo y potasio a la luz del sol para producir fosforescencia y luego colocó el material sobre una placa fotográfica forrada con papel negro (que bloquearía la luz visible, pero no los rayos X). De estarse produciendo rayos X al incidir el sol en el material, este debería de velar la placa fotográfica. Esto fue justo lo que encontró. Contaba Becquerel que unos días nublados lo llevaron a interrumpir sus experimentos, por lo que guardó la sal sin exponer sobre una placa fotográfica forrada, en un cajón oscuro. Días después, reveló la placa y para su sorpresa, encontró que la placa fotográfica se había velado en donde estuvo en contacto con la sal (Figura 2). Esto no debería de haber ocurrido, dado que la sal no estuvo iluminada por el sol. Razonó entonces que esto no tenía que ver con los rayos X, sino con la emisión natural de energía por la sal. Había descubierto la radioactividad natural, producida en este caso por el uranio existente en la sal.

Figura 2. La placa fotográfica original de Becquerel, mostrando la radioactividad natural. Las manchas negras en la placa corresponden a los puntos donde estuvo en contacto con la sal doble de uranilo y potasio. Note que la mancha inferior presenta una cruz, debido a haber puesto una cruz metálica entre la sal y la placa fotográfica. (Fuente: https://commons.wikimedia.org/wiki/File:Becquerel_plate.jpg).
El hallazgo causó profundo interés y fue ampliado por Marie Curie y Pierre Curie, quienes encontraron que, además del uranio, otros elementos como el radio, el torio y el polonio también eran naturalmente radiactivos. Por sus hallazgos, Becquerel y los esposos Curie recibirían el Premio Nobel de Física en 1903. El impacto de este descubrimiento fue enorme, al promover la investigación en la energía nuclear, para bien y para mal.
Un cultivo bacteriano contaminado
En 1928, el científico inglés Alexander Fleming estaba estudiando un grupo de microorganismos, los estafilococos, causantes de graves enfermedades en humanos. En ese entonces, las enfermedades bacterianas podían causar la muerte. Había pocas alternativas para curarlas, basadas principalmente en la respuesta inmune del propio paciente o eventualmente la vacunación. Fleming ya había empleado sin éxito una sustancia producida por otra bacteria, la lisozima. Aunque esta sustancia podía atacar a las células de estafilococo, no era eficiente para curar una infección. En el curso de sus estudios, Fleming empleaba cajas de Petri con un medio de cultivo sólido, como una gelatina, donde los estafilococos crecían formando colonias.
Un día, Fleming notó que una de sus cajas de cultivo se había contaminado con una colonia de un hongo. ¡Qué fastidio! A punto de desechar la caja de cultivo, notó que alrededor de donde crecía la colonia del hongo, no había crecimiento de colonias de estafilococo (Figura 3A).
Figura 3. El hallazgo de la penicilina. A, el cultivo original de Fleming, mostrando la inhibición del crecimiento de colonias de estafilococos por la acción de Penicillium (1); B, estructura de la penicilina (imagen de Wikipedia).
Sospechando que el hongo estaba produciendo una sustancia que inhibía o mataba a los estafilococos, aisló el hongo (posteriormente identificado como Penicillium notatum), lo cultivó en un medio líquido y filtró el medio donde había crecido P. notatum. Encontró que el filtrado del cultivo efectivamente mataba a las células de estafilococo y no solamente a ellas: era efectivo para matar a otras bacterias, como estreptococos, neumococos, gonococos y Corynebacterium diphteriae, causantes todas ellas de enfermedades humanas. Más aún, estos filtrados no eran tóxicos para animales (1). Por azar y sagacidad (esto es, por serendipia) había encontrado el primer antibiótico, la penicilina (Figura 3B).
La aplicación de este conocimiento para tratar enfermedades en humanos tuvo que esperar al desarrollo de métodos para producir industrialmente la penicilina, método desarrollado por Howard Florey y Ernst Chain. La penicilina fue utilizada sistemáticamente durante la Segunda Guerra Mundial, para prevenir y combatir infecciones en soldados heridos, salvando incontables vidas. Por su trabajo, Fleming, Florey y Chain recibieron el Premio Nobel de Fisiología y Medicina en 1945. Aún más importante, su trabajo inspiró a numerosos investigadores a buscar nuevos antibióticos, que ayudaron a controlar numerosas infecciones que antes llevaban a una muerte temprana. Sí, vivimos en una era de los antibióticos, en la cual, gracias a la vacunación y los antibióticos, dejamos de preocuparnos por las enfermedades bacterianas. Resulta triste que estos logros en salud pública ahora se encuentren amenazados, en un caso por el uso excesivo y a veces irracional de antibióticos y en el otro por los movimientos antivacunas. El regreso de las enfermedades bacterianas, con su cauda de infortunios, sería una tragedia.
De bacterias en un campo eléctrico al tratamiento del cáncer
El científico norteamericano Barnett Rosenberg tenía un interés muy especial. Siendo biofísico de formación, le interesaba conocer el efecto de los campos eléctricos sobre el crecimiento y división de células vivas, en particular de la bacteria Escherichia coli. Entre 1964 y 1965 ideó un experimento para explorar estos efectos. Puso a crecer células de E. coli en un medio de cultivo líquido (un caldo de cultivo), en una cámara especialmente adaptada para pasar una corriente eléctrica en el medio de cultivo. Sí, bacterias electrocutadas. Al realizar este experimento, encontró que las bacterias que no habían sido sometidas a una corriente eléctrica crecían sin problemas, con su forma bacilar normal, similar a un bastón (Figura 4A). En contraste, si aplicaba una corriente eléctrica, las bacterias se desarrollaban como largos filamentos, hasta 300 veces mayores en tamaño que una bacteria normal, dejando eventualmente de crecer (2). Entusiasmado por esto, se dispuso a estudiar el por qué una corriente eléctrica tenía este efecto sobre las células, hasta que se decepcionó. La electricidad por sí sola no era la causante del efecto. El efecto era causado por la electricidad, pero provocando una reacción de compuestos químicos presentes en el medio de cultivo con el platino de los electrodos usados para aplicar una corriente eléctrica, produciendo un compuesto nuevo (posteriormente identificado como cisplatino, Figura 4C), el cual afectaba el desarrollo de las células.

Figura 4. Efecto de una corriente eléctrica sobre el crecimiento de Escherichia coli. A, bacterias crecidas sin electricidad; B, bacterias crecidas con electricidad. El efecto es causado por la producción de cisplatino bajo electricidad (C). Compuestos como el carboplatino y el oxaliplatino (C) tienen el mismo efecto.
Como podrán imaginarse, Rosenberg dejó de interesarse en la electricidad y decidió estudiar el efecto del cisplatino sobre otras células, especialmente las células cancerosas. Encontró que el cisplatino puede inhibir y aún matar células cancerosas no solamente en cultivo, sino inclusive hacer desaparecer tumores en animales de experimentación, como ratones (3). Esto motivó una gran cantidad de estudios que demostraron la efectividad del tratamiento con cisplatino para combatir el cáncer en pacientes humanos (4). Actualmente el cisplatino y sus derivados, como carboplatino y oxaliplatino, son usados como terapia en cánceres de pulmón, vejiga, cuello uterino, ovario y testículo. Para el cáncer testicular, se le considera inclusive una cura. Antes de la introducción del cisplatino y sus derivados, la sobrevivencia a cinco años de pacientes diagnosticados con cáncer testicular era menor al 10%. Ahora, bajo tratamiento con cisplatino o sus derivados, la sobrevivencia es superior al 90% (4). Su efectividad parece deberse a la modificación del ADN de las células cancerosas, provocando su muerte (4). De bacterias en un campo eléctrico a una efectiva terapia anticancerosa... ¿quién podía imaginarlo?
De los monstruos de Gila a la diabetes tipo 2
Los monstruos de Gila (Heloderma suspectum, Figura 5A) son animales interesantes: un tipo de lagarto de 40 a 50 cm de largo que vive en los desiertos del norte de México y el sur de los Estados Unidos, de movimiento muy lento y con una saliva que es tóxica para sus presas, inclusive para el humano. Uno de sus primos, el lagarto enchaquirado (Heloderma horridum, Figura 5B) es nativo de México y también produce una saliva venenosa. Ambas especies son muy estudiadas para conocer los componentes tóxicos en su saliva, con la intención de desarrollar antivenenos. El monstruo de Gila tiene también una propiedad muy especial: es capaz de sobrevivir por periodos muy largos con una frecuencia de alimentación reducida, en algunos casos de solo seis veces en el transcurso de un año. Eso sí, cuando comen, se atascan: pueden llegar a ingerir alimentos que representan un 20% de su propio peso. Evidentemente su lento movimiento ayuda a sobrevivencia en situaciones de poco alimento, pero debería de tener alguna manera de manejar más eficientemente la glucosa, esencial para la supervivencia.

Figura 5. A, el monstruo de Gila (Heloderma suspectum); B, el lagarto enchaquirado (Heloderma horridum); C, Ozempic, un medicamento para control de obesidad y diabetes, desarrollado del conocimiento obtenido con el monstruo de Gila.
Intrigados por esta característica, los norteamericanos John Eng y Jean-Pierre Raufman empezaron a estudiar a este animal en la década de 1990. Para su sorpresa, encontraron que en la saliva del monstruo de Gila se produce una hormona, de naturaleza peptídica (esto es, compuesta de unos pocos aminoácidos), la cual llamaron exendina-4 (5). Esta hormona estimula la producción de insulina, que ayuda al ingreso de la glucosa a las células. La exendina-4 es similar a una hormona producida en la especie humana, llamada GLP-1, que también promueve la producción de insulina. Sin embargo, hay una importante diferencia: la exendina-4 es más estable, promoviendo la producción de insulina por un tiempo más largo que lo que logra GLP-1. Cuando los monstruos de Gila se alimentan, la producción de exendina-4 retrasa el vaciado del estómago (promoviendo una digestión más prolongada) y también estimula la absorción de glucosa por las células. Otro efecto de la exendina-4 es la producción de cambios en las células intestinales que mejoran la absorción de nutrientes por un tiempo muy largo (6). La producción de exendina-4 explicaba la supervivencia del monstruo de Gila en condiciones con poco alimento, pero también abría una interesante posibilidad. ¿Podrían introducirse los cambios observados en exendina-4 a la GLP-1 humana para aumentar su estabilidad y tiempo de acción? De lograrse esto, podría convertirse en un tratamiento para enfermedades que afectan el manejo de glucosa, como la diabetes tipo 2.
Llevó años de experimentación y la participación de científicos tanto en instituciones públicas como en empresas, pero en 2005 se aprobó el uso de un medicamento conocido como Exenatide (comercializado como Byetta o Bydureon) para tratamiento de la diabetes tipo 2. Más recientemente, se han desarrollado medicamentos como el Ozempic (Figura 5C) para tratamiento de la obesidad y la diabetes tipo 2 (7).
El aspecto de serendipia en este ejemplo es que los investigadores estaban interesados en un principio en estudiar la fisiología de los monstruos de Gila y cómo podían sobrevivir con una escasa frecuencia de alimentación. Si bien sospechaban la participación de hormonas en este proceso, no esperaban la explicación (el efecto prolongado de exendina-4) y que este pudiera ser aplicado a una enfermedad humana. La vida te da sorpresas...
Hay que apoyar a la ciencia
En este artículo les presenté cinco ejemplos de la serendipia en el campo de la investigación científica. Podría haber presentado muchos más: el desarrollo de productos como la Kola-Loka (Super Glue en Estados Unidos), el Velcro o el horno de microondas también son ejemplos de serendipia. Lo mismo pasa con el desarrollo de procesos, como la ingeniería genética y la edición genética con CRISPR-Cas9. Común a todos ellos, además de la serendipia, es el papel imprescindible de la ciencia básica en estos logros. ¿Quién podría predecir que estudios sobre la fluorescencia, la fosforescencia, hongos contaminantes, bacterias electrocutadas y dietética de monstruos de Gila podría llevar a conocimientos que transforman nuestras vidas?
Necesitamos tanto de ciencia básica como de ciencia aplicada. Una no está encima de la otra ni una es preferible a otra, a pesar de lo que parecen pensar algunos políticos e ideólogos de miras estrechas, frecuentemente sexenales. Se necesitan de ambas, de su primo práctico, la tecnología, y de financiamiento público y privado. Siempre que queramos ceder ante aquellos que prefieran una sobre la otra, recordemos la frase de George Porter, Premio Nobel de Química en 1967: “Alimentar la ciencia aplicada privando a la ciencia básica es como economizar en los cimientos de un edificio para construirlo más alto. Es solo cuestión de tiempo antes de que todo el edificio se derrumbe”.
Desde luego, la ciencia por curiosidad es característica de la especie humana. Siempre que nos preguntamos ¿qué pasa? ¿cómo pasa? estamos haciendo una actividad que iniciamos desde niños, cuando comenzamos a conocer nuestro entorno. Ruy Pérez Tamayo lo decía mejor de lo que puedo hacerlo yo: “Los aspectos más importantes y valiosos de la ciencia para el hombre (...) son la liberación de prejuicios oscurantistas a través del conocimiento de la naturaleza y de sí mismo, permitiéndole una vida más natural y más de acuerdo con su verdadero sitio en el orden de las cosas, así como proporcionarle la aventura intelectual más estimulante para niños y adultos que existe en este mundo”.
Referencias
- Fleming, A. (1929). On the antibacterial action of cultures of a Penicillium, with special reference to their use in the isolation of B. influenzae. Br J Exp Pathol. 10, 226–236. Disponible en: https://pmc.ncbi.nlm.nih.gov/articles/PMC2048009/
- Rosenberg, B., Camp, L. V., y Krigas, T. (1965). Inhibition of cell division in Escherichia coli by electrolysis products from a platinum electrode. Nature 205, 698–699. doi: 10.1038/205698a0
- Rosenberg, B., Vancamp, L., Trosko, J. E., y Mansour, V. H. (1969). Platinum compounds: a new class of potent antitumour agents. Nature 222, 385–386. doi: 10.1038/222385a0
- Ali, R., Aouida, M., Sulaiman, A. A., Madhusudan, S., y Ramotar, D. (2022). Can cisplatin therapy be improved? Pathways that can be targeted. Int. J. Mol. Sci. 23, 7241. doi: 10.3390/ijms23137241
- Eng, J., Kleinman, W. A., Singh, L., Singh, G., y Raufman, J. P. (1992). Isolation and characterization of exendin-4, an exendin-3 analogue, from Heloderma suspectum venom. Further evidence for an exendin receptor on dispersed acini from guinea pig pancreas. J. Biol. Chem. 267, 7402–7405. doi: 10.1016/s0021-9258(18)42531-8
- Christel, C. M., DeNardo, D. F., y Secor, S. M. (2007). Metabolic and digestive response to food ingestion in a binge-feeding lizard, the Gila monster (Heloderma suspectum). J. Exp. Biol. 210, 3430–3439. doi: 10.1242/jeb.004820
- Abuchaibe, R. El monstruo de Gila, el lagarto con digestión lenta que fue clave para la creación de Ozempic, el revolucionario medicamento contra la obesidad. BBC News Mundo, 6 de marzo de 2025. https://www.bbc.com/mundo/articles/c7vz7vemr48o
Esta columna se prepara y edita semana con semana, en conjunto con investigadores morelenses convencidos del valor del conocimiento científico para el desarrollo social y económico de